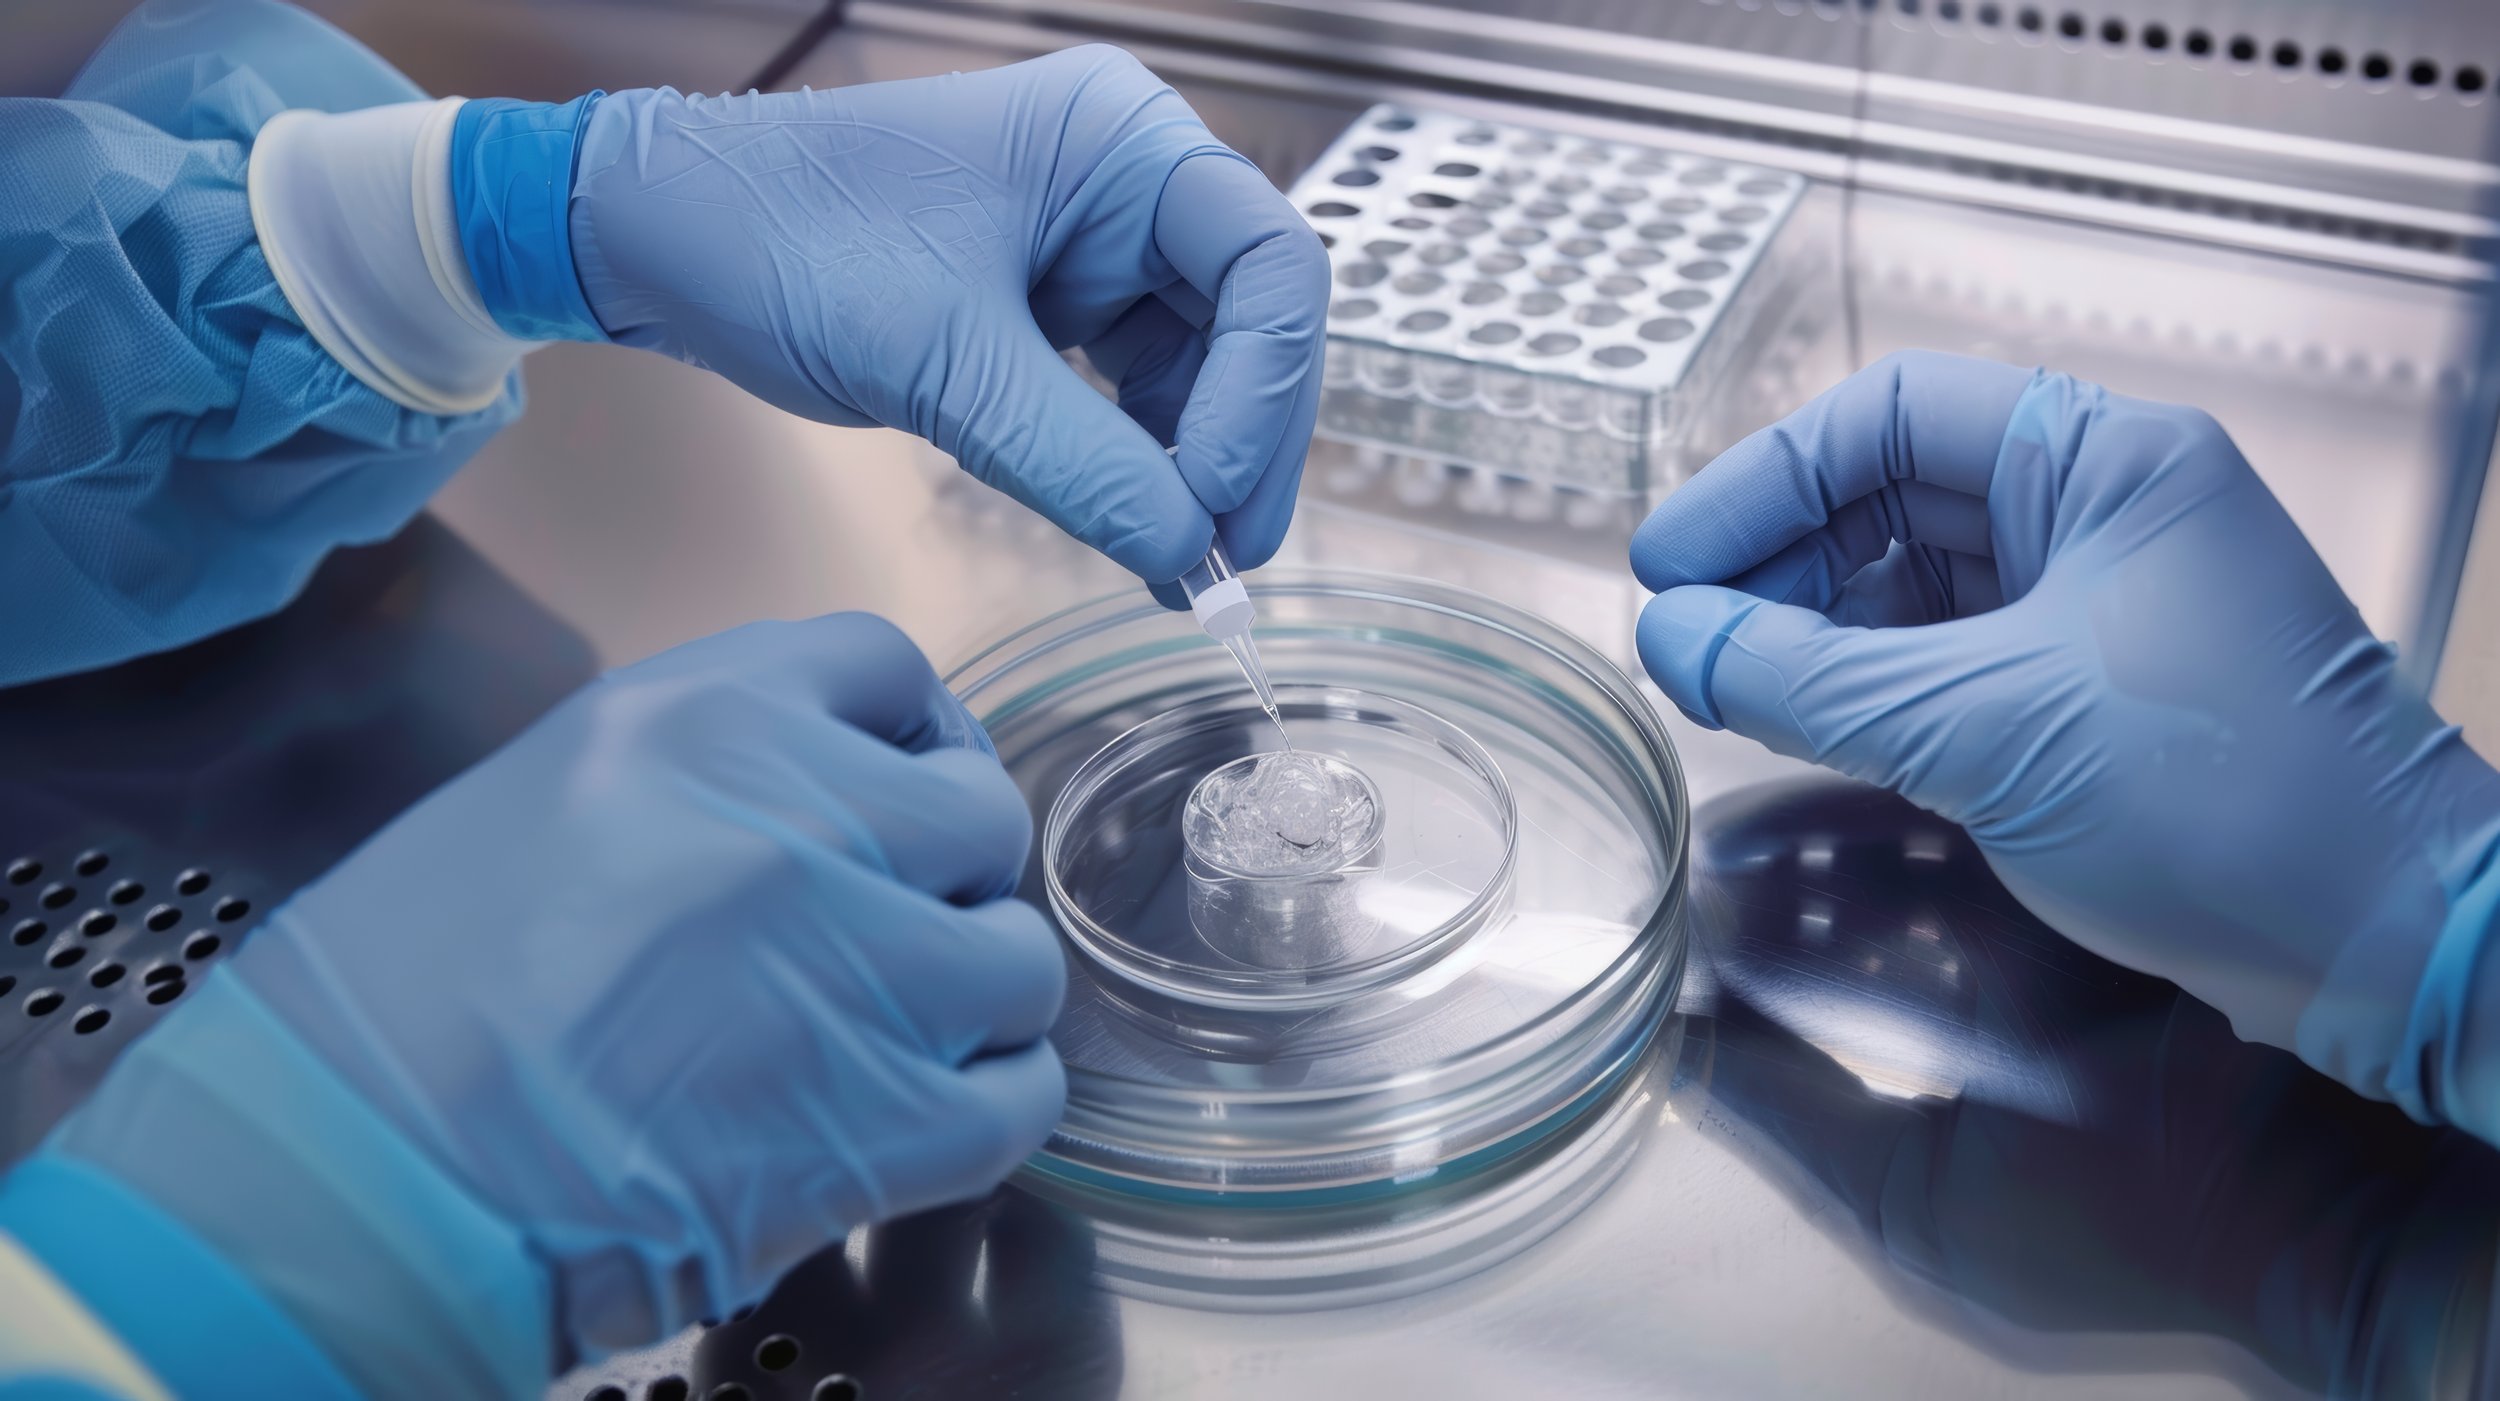

Quiénes somos
En IKI KAI somos una empresa dedicada a proveer insumos y equipos médicos de excelencia para medicina reproductiva, cirugía mínimamente invasiva, urología, ginecología y obstetricia.
Nuestro compromiso es facilitar el trabajo de médicos, biólogos y especialistas, integrando tecnología y calidad para optimizar sus labores. Inspirados en la precisión y conexión, trabajamos para ofrecer soluciones innovadoras que marcan la diferencia en cada procedimiento, contribuyendo al bienestar de pacientes y profesionales en todo Chile.